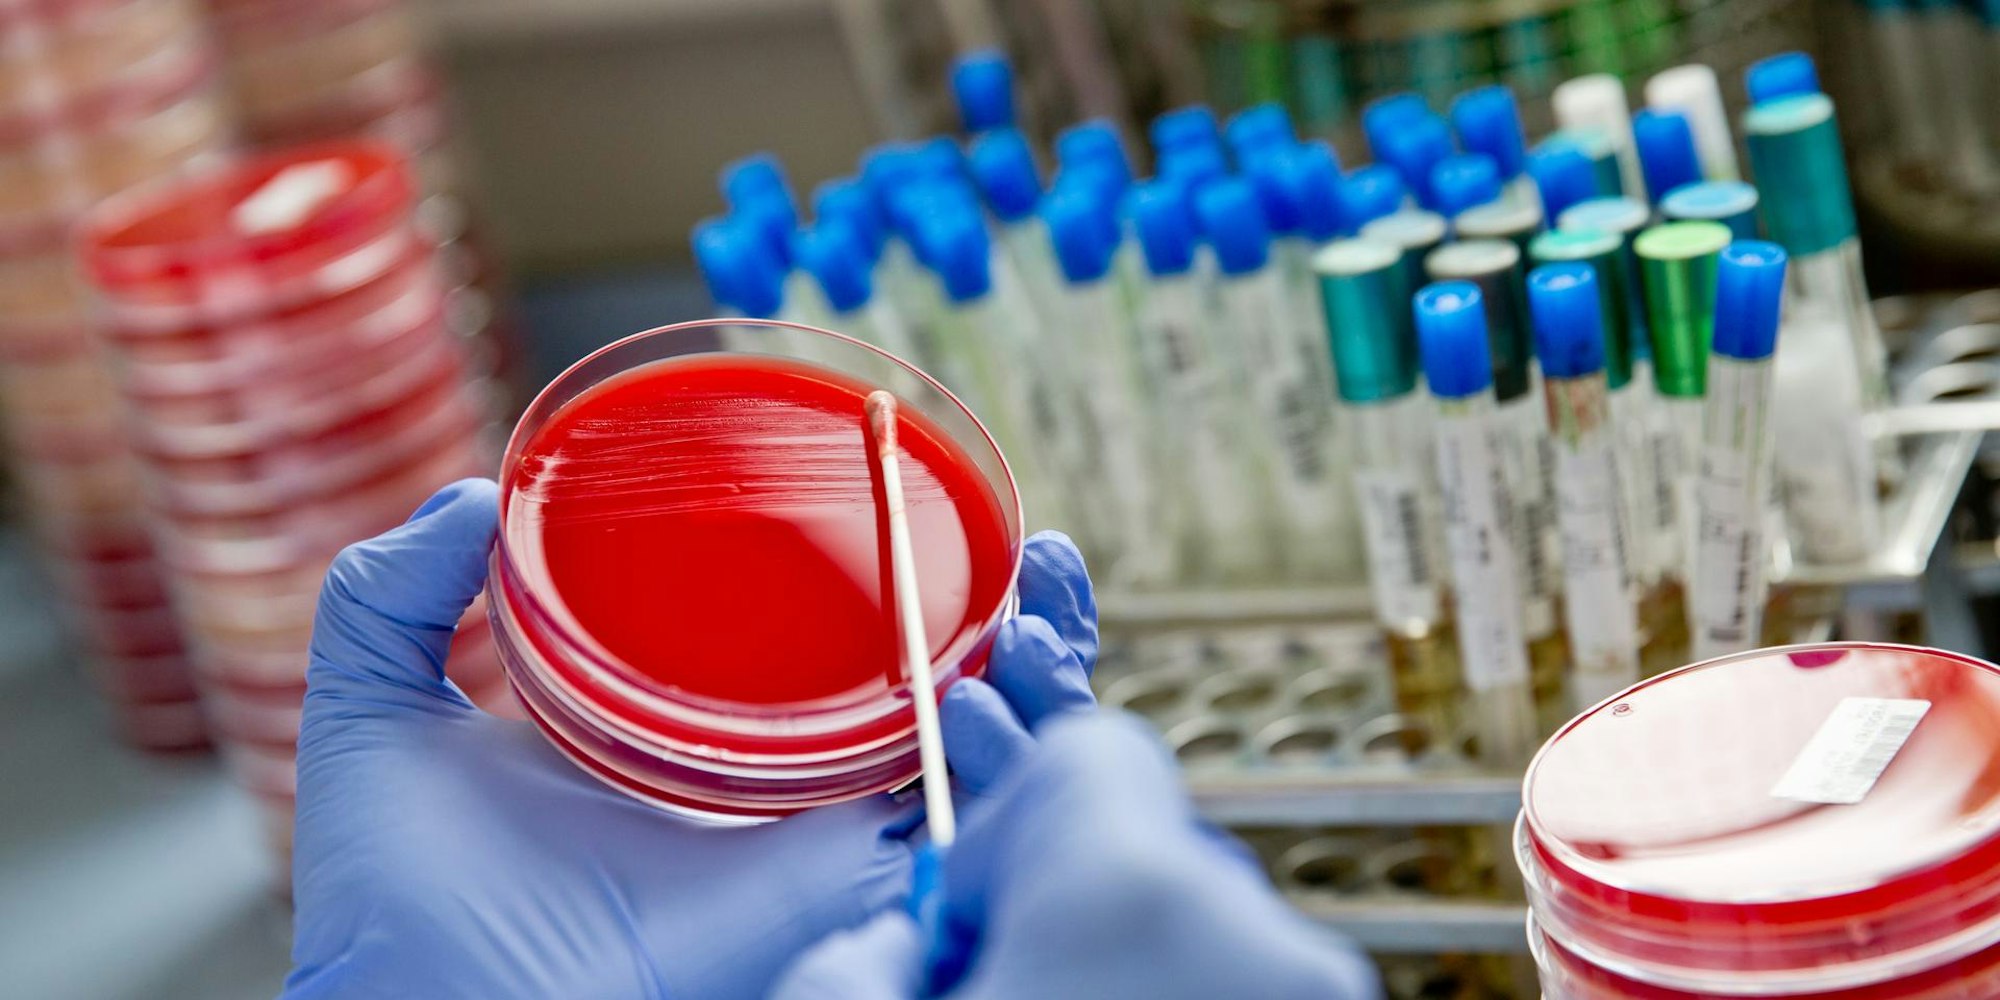
Neuer Inhalt (1)

Keime in Kölner Praxis„Einer der größten Ausbrüche mit dem Erreger überhaupt”
Mindestens 28 Menschen sollen sich mit den Keimen infiziert haben (Symbolbild).
Copyright: picture alliance / Daniel Karman
- In der Kölner Radiologiepraxis des Medizinischen Versorgungszentrums in der Zeppelinstraße haben sich 28 Patienten mit einem gefährlichen Bakterium angesteckt.
- Experte Peter Walger erklärt, warum dieser Kölner Fall von großer Bedeutung ist und was denjenigen passieren kann, die sich mit dem gefährlichen Keim infizieren.
Köln – In einer Kölner Radiologiepraxis haben sich infolge einer Spritzen-Therapie im Bereich der Wirbelsäule 28 Patienten mit dem Erreger Pseudomonas aeruginosa infiziert. Wie beurteilen Sie das Ausmaß?
Es handelt es sich um einen der größten Ausbrüche mit dem Erreger in einer ambulanten medizinischen Einrichtung überhaupt, beschrieben worden ist in ganz Europa meines Wissens nach noch kein größerer Ausbruch.
Das Kölner Gesundheitsamt sagt, „unverzüglich nach Bekanntwerden des Verdachts informiert worden zu sein“. Zu dem Fall äußert sich die Behörde aus Datenschutzgründen nicht. Ist das so üblich?
So wie ich den Fall als Außenstehender einschätze, haben die Beteiligten richtig gehandelt: Das Amt und ein externes Hygienemanagement wurden eingeschaltet, es wurde mit den Verantwortlichen der Praxis nach der Keimquelle gesucht, die Therapie wurde ausgesetzt, die Patienten wurden informiert. Inzwischen ist auch die Staatsanwaltschaft offenbar durch Selbstanzeige eingeschaltet. Über die zeitlichen Abläufe kann ich natürlich nichts sagen.
Das könnte Sie auch interessieren:
Wann müssen Keim-Infektionen infolge von Injektionen gemeldet werden?
Bei mehr als einer Infektion, wenn ein kausaler und zeitlicher Zusammenhang zwischen den Infektionen wahrscheinlich ist. Voraussetzung ist, dass es sich um Infektionen in einer Klinik oder Praxis handeln.
Angenommen, bei zwei Patienten träten in kurzer Folge Komplikationen auf: Was wäre dann zu tun?
Wenn es sich bei der Komplikation um Infektionen handelt und der Verdacht eines kausalen und zeitlichen Zusammenhanges bei der Entstehung besteht, muss ein Ausbruchsverdacht geäußert werden. Hieraus folgen eine sofortige Meldung an das Gesundheitsamt und weiterer Aufklärungsbedarf. Hier beginnt ein sogenanntes Ausbruchsmanagement: Benennung eines Teams, das das Geschehen erfasst, Maßnahmen festlegt, die zum Stopp einer Ausbreitung der Infektionen beitragen und die Suche nach der Ursache veranlasst.
Die Praxis schrieb an potenziell betroffene Patienten: „Wie wir jetzt wissen, dauert es eine recht lange Zeit, bis es nach der Therapie zu Infektionssymptomen kommt (ca. zwei bis vier Wochen).“ Wie ist die durchschnittliche Inkubationszeit des Erregers Pseudomonas aeruginosa?
Das kann Minuten bis zu Stunden oder auch Tage dauern, je nach Art und Weise des Eintritts des Erregers in den betroffenen Patienten. Im Falle einer Injektion in die Blutbahn oder in das Hirnwasser kann es zu einer unmittelbaren und gegebenenfalls tödlichen akuten Infektion kommen. Im Falle einer Übertragung durch kontaminierte Gegenstände oder Hände kann zunächst eine reine Besiedlung mit dem Erreger entstehen, aus der sich später eine Infektion entwickeln kann. Die Fragen der Praxis bezogen sich wohl am ehesten auf Letzteres, weil Patienten befragt wurden, deren Behandlung länger zurück lag. Bei akut erkrankten Patienten muss man vermuten, dass diese zum Teil notfallmäßig nach der Behandlung in Krankenhäusern aufgenommen wurden.
Ist das in Köln übertragene Bakterium besonders aggressiv?
Pseudomonas aeruginosa gehört mit zu den gefährlichsten in Krankenhäusern vorkommenden bakteriellen Infektionserregern, vorausgesetzt das Bakterium gelangt in den menschlichen Körper, das heißt in normalerweise keimfreie Bereiche. Je nachdem, wo der Eintritt ist und wohin der Erreger dann gelangt, werden unterschiedlich schwere und ausgedehnte Infektionen verursacht. Rein oberflächlich kann Pseudomonas aeruginosa kleinere und größere Hautläsionen, Wunden oder Verletzungen besiedeln, mehr oder weniger schwere Infektionen verursachen und auch in tiefere Gewebe vordringen, das heißt auch zu Knocheninfektionen führen. Gelangt er in die Lunge, kann das zu Pneumonien führen. Im Falle eines Ausbruchsgeschehens durch kontaminierte Spritzen oder Erregerhaltige Injektionslösungen oder Medikamente führt das zu Infektionen je nach dem Ort der Injektionen. Am gefährlichsten sind dabei Injektionen direkt in die Blutbahn oder in das Hirnwasser, die eigentlich niemals passieren dürften.
Lässt sich etwas zur Häufigkeit von Infektionen durch verunreinigte Geräte sagen?
Es gibt keine verlässlichen Gesamtzahlen, aber es gibt zahlreiche Beispiele für Ausbrüche, auch durch Pseudomonas aeruginosa, bei denen Verunreinigungen z.B. in Endoskopen ursächlich waren.
Wo ist der Keim am häufigsten zu finden?
Pseudomonas aeruginosa ist ein Umweltkeim, der sich besonders günstig in Flüssigkeiten verbreitet und sich auch dort besonders gut vermehrt. Meist kommt das Bakterium deshalb in feuchten Bereichen vor. Feuchtigkeit ist auch ein kritischer Faktor bei Infektionsreservoiren für Pseudomonas aeruginosa im Krankenhausumfeld oder in anderen medizinischen Einrichtungen. Im Zusammenhang mit Ausbrüchen fand man ihn in Spül- und Reinigungslösungen, in Desinfektionsmitteln, in Medikamentenzubereitungen, in den Wasserführenden Systemen des Krankenhauses zum Beispiel in Waschbecken- oder Duschabflüssen, in Spülrändern von Toiletten, in Putzfeudeln oder an medizinischen Geräten, die mit kontaminiertem Wasser gewaschen waren. Pseudomonas aeruginosa kann auch beim Menschen vorkommen, wobei die Besiedlung beim Gesunden außerhalb des Krankenhauses in der Regel sehr gering ist. Die ursächlichen Quellen für Pseudomonas aeruginosa-Infektionen beim Menschen und die präzisen Übertragungswege bleiben häufig unklar. Im Rahmen eines Ausbruchs muss nach der Quelle intensiv und systematisch gesucht werden.
In Köln haben mindestens drei Patienten infolge der Behandlung eine Hirnhautentzündung erlitten. Können Sie etwas zur Wahrscheinlichkeit von Hirnhautentzündungen infolge von verunreinigten Spritzen im Wirbensäulenbereich sagen?
Wenn es sich um eine Injektion eines Medikamentes aus einer mit dem Erreger kontaminierten Spritze handelt oder wenn das Medikament oder Lösungsmittel selbst erregerhaltig ist und die Injektion versehentlich in das Hirnwasser selbst erfolgt, kommt es unmittelbar zu einer Infektion der Rückenmarks- und Hirnhäute beziehungsweise des Gehirns, das heißt zu einer Meningitis oder Meningoenzephalitis, und zwar bei Pseudomonas aeruginosa mit einer 100%-igen Wahrscheinlichkeit. Sofern regulär rückenmarksnah, das heißt außerhalb des Hirnwasserraums gespritzt wird, so wie es im vorliegenden Fall beschrieben wird, entsteht eine Infektion im Bereich des Spritzkanals, der angrenzenden Weichteile oder der naheliegenden Wirbelkörper beziehungsweise Zwischenwirbelräume. Das generelle Risiko für eine Meningitis bei regulärer Durchführung dieser Therapieform ist extrem selten, es liegt bei ca. 1:500 000.
Hat es vor dem Kölner Fall schon einmal Infektionen mit dem Keim nach Spritzen gegeben? Sind Resistenzen bei diesem Keim besonders gefährlich?
Ausbrüche mit Pseudomonas aeruginosa durch Erreger-kontaminierte Injektionen im Rahmen von Schmerzbehandlungen bei Patienten mit Rückenschmerzen sind in der Literatur beschrieben. Unabhängig von der Resistenz des Keims ist der Eintrag des Erregers primär gefährlich, kann zu schwersten Infektionen und potenziell auch zum Tod führen. Die Resistenz muss immer konkret analysiert werden und definiert dann die Therapiemöglichkeiten. Pseudomonas aeruginosa ist ein Erreger, bei dem häufig Resistenzen nachgewiesen werden und dessen Behandlung sehr schwierig sein kann.
In Köln scheint der Ausbruch sehr spät bemerkt worden zu sein. Einige Patienten, die Symptome deuten konnten, berichten, erst Wochen später informiert worden zu sein. Woran kann das liegen?
Das Erkennen eines Ausbruchs bei ambulant behandelten Patienten, der erst durch Infektionen in verschiedenen Krankenhäusern manifest wird, hängt am ehesten davon ab, an welcher Stelle als Erstes auffällt, dass es eine Häufung von Infektionen durch denselben Erreger gibt und dass eine gemeinsame Ursache vermutet wird. Das kann sowohl ein mikrobiologisches Labor sein, das Befunde mehrerer Patienten dieses Ausbruches untersucht hat oder ein Krankenhaus, in dem mehrere Patienten behandelt werden, die zuvor in einer Praxis behandelt wurden.
Stehen wir vor einer Zeit, in der Antibiotika nicht mehr wirken, weil es so viele Resistenzen gibt?
Weltweit warnen alle verantwortlichen Institutionen vor einer dramatischen Zunahme von Todesfällen durch Infektionen, die durch multiresistente Erreger verursacht werden. In Einzelfällen gibt es bereits Infektionen durch Erreger, gegen die es kein einziges zugelassenes Antibiotikum gibt. Noch sind die Zahlen in Deutschland gering, aber der Trend und die globale Lage sind bedrohlich. Die Hauptursachen der aktuellen Resistenzentwicklungen liegen in der Anwendung von Antibiotika in der Humanmedizin. Generell werden Antibiotika viel zu häufig eingesetzt, daher entstehen immer mehr Resistenzen.
700.000 Tote pro Jahr
Das europäische Netzwerk zur Beobachtung antimikrobieller Resistenzen geht von 33 000 Todesfällen im Jahr 2015 aus, die auf multiresistente Erreger (MRE) zurückzuführen seien. In Deutschland seien rund 2300 Menschen so verstorben. Studien gehen von weltweit 700 000 Todesfällen pro Jahr nach Infektionen aus, gegen die keine Antibiotika mehr helfen. (uk)
Woran liegt es, dass in den Niederlanden einige resistente Keime in Krankenhäuser deutlich seltener anzutreffen sind?
Eindeutig finden sich niedrigere Resistenzraten bei der Bakterienart Staphylococcus aureus und seiner Methicillin-resistenten Variante MRSA. Historische Gründe sind unter anderem eine frühzeitige konsequente Suche nach dem Erreger bei der Patientenaufnahme ins Krankenhaus und anschließend eine strikte Isolation („search and destroy“ Strategie). Zudem werden mehr Patienten ambulant versorgt. Es gibt mehr Infektiologen und klinisch geschulte Pharmakologen, die über den Einsatz von Antibiotika wachen. Allerdings hat es auch in den Niederlanden Ausbrüche mit Problem-Erregern gegeben und die Rate von Krankenhausinfektionen ist nicht niedriger als in Deutschland.
Sind Reinigungskräfte ausreichend geschult, um Krankheitserreger nicht weiter zu verbreiten?
Grundsätzlich werden Reinigungskräfte in Krankenhäusern regelmäßig geschult. Entsprechende Regeln sind vorhanden und müssen auch umgesetzt werden. Die Defizite liegen aber offen erkennbar an verschiedenen Fakten, die die Realität in den Krankenhäusern bestimmen. Outsourcing der ehemals klinikeigenen Reinigungsdienste in private Unternehmen, häufig fehlende Sprachkenntnisse bei Mitarbeitern der Fremdfirmen, schlechtere Bezahlung der Reinigungsarbeit, die häufig nach Leistungsgrößen reinigen, die in normalen Arbeitszeiten nicht oder nur mit Qualitätseinbußen erzielt werden können, fehlende Bereitstellung einer kompletten desinfizierenden Reinigung an sieben Tagen der Woche zu jeweils 24 Stunden. In vielen Kliniken nur Sichtreinigung an Wochenenden, Feiertagen und an einzelnen Tagen der Woche.


